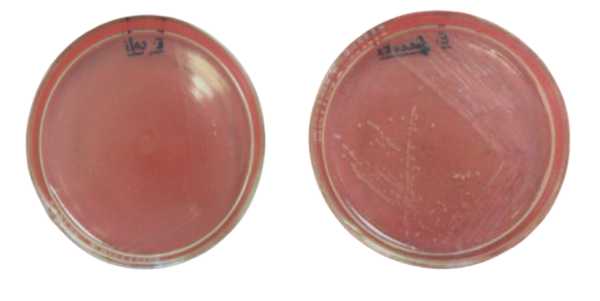
- PEA agar plates without blood incubated at 48 hours at 35°CLeft:Escherichia coli.Right:Enterococcus faecalisImage source: Cheeptham and Farday, ASM MicrobeLibrary

Phenylethyl alcohol agar (PEA) is a selective medium used to cultivate Gram-positive organisms, particularly cocci, from a sample containing a mixture of pathogens. The active ingredient, phenylethyl alcohol, inhibits or markedly reduces the growth of Gram-negative organisms by interfering with DNA synthesis. Staphylococcus aureus, a Gram-positive organism, grows on PEA while Serratia marcescens, a Gram-negative organism, does not.
Principle
Phenylethyl alcohol agar (PEA) is a selective medium that permits the growth of gram-positive cocci while inhibiting most gram-negative organisms. PEA alters the membrane permeability, of Gram-negative bacteria allowing influx of otherwise blocked molecules. This results in leakage of large amounts of cellular potassium that ultimately results in disruption or inhibition of DNA synthesis of Gram-negative bacteria.
Composition of PEA
PEA agar medium can be purchased as a premixed powder from suppliers. The manufacturer’s instructions should be followed to prepare the plates. This media can also be purchased as premade agar plates.
| Ingredients | Amounts (gm/L) |
|---|---|
| Pancreatic digest of casein | 15.0 g |
| Papic digest of soybean meal | 5.0 g |
| Sodium chloride | 5.0 g |
| Agar | 15.0 g |
| Sterile defibrinated sheep blood | 50.0 ml |
| β-Phenylethyl alcohol | 2.5 g |
| Distilled water | 1 liter |
Final pH at 25°C 7.3 ± 0.2.
Preparation of the Media
Phenylethyl alcohol agar (PEA) may be prepared with and without 5% sheep blood supplement. Five percent sheep blood is added to the base medium to enhance the growth of anaerobic bacteria.
| Characteristics | PEA without sheep blood | PEA with 5% sheep blood |
|---|---|---|
| Color of the prepared media | clear to slightly hazy and pale yellow. | firm, opaque, and red in color. |
| Shelf live | prepared plates can be stored in the refrigerator for up to 4 weeks before use. | prepared plates could be stored in the refrigerator up to 1 week before use. |
Step no. 5 is required while preparing PEA with 5% sheep blood supplementation.
Note:
Culture
Inoculation
Stored media should be brought to room temperature before inoculation.
Aseptically transfer potentially mixed cultures onto the surface of the agar using a streaking or spreading technique, depending on the objectives of the study.
Incubation
Incubate plates for 24 to 48 hours at 35°C ± 2 °C in an appropriate atmosphere. Depending on the objectives of the study, PEA blood agar plates can be incubated under aerobic, anaerobic, and 5% CO2 atmosphere. Incubation in a high CO2 atmosphere allows the detection of bacteria that require an increased CO2 concentration and also results in better growth of almost all of the other pathogens.
Interpretation of results
After proper incubation growth of bacteria will appear as colonies on the surface of agar plates. Gram-positive bacteria demonstrate good growth while most gram-negative bacteria do not grow or are partially inhibited.

Growth Response
Growth response of some gram-positive and gram-negative bacteria on PEA agar
| Organism | Gram reaction | Growth response |
|---|---|---|
| Escherichia coli | Gram-negative | Inhibited |
| Enterobacter aerogenes | Gram-negative | Inhibited |
| Proteus mirabilis | Gram-negative | Markedly inhibited. Swarming inhibition. |
| Pseudomonas aeruginosa | Gram-negative | Partially inhibited |
| Salmonella enteritidis | Gram-negative | Inhibited |
| Bacillus sp. | Gram-positive | Good |
| Clostridium perfringens | Gram-positive | Partially inhibited |
| Enterococcus faecalis | Gram-positive | Good |
| Micrococcus luteus | Gram-positive | Good |
| Staphylococcus aureus | Gram-positive | Good |
| Streptococcus pneumoniae | Gram-positive | Good |
| Streptococcus pyogenes | Gram-positive | Good |
Uses
- PEA agar is used if the sample source contains a mixture of pathogens (e.g., gastrointestinal content or peritoneal fluid) or Gram stain indicates that the culture contains Gram-negative rods. Phenylethyl alcohol agar inhibits gram-negative bacteria, specifically Proteusspecies, in specimens containing mixed bacterial flora. It is used for the selective growth of Staphylococcusand Streptococcus inmixed cultures.
- PEA agar with 5% sheep blood is used to isolate most gram-positive and gram-negative anaerobes fromenteric samples. It inhibits facultative gram-negative rods, preventing Enterobacteriaceaefrom overgrowing the anaerobes and inhibiting the swarming of Proteusand Clostridium septicum.
Limitations
- Some gram-positive cocci may be slightly inhibited by PEA and many require incubation up to 48 hours for sufficient growth to be visible.
- Pesudomonas aeruginosa(a gram-negative bacteria) is not inhibited on this medium. Other gram-negatives sometimes may give tiny observable colonies but they are often confined to the first quadrant on a streak plate.
References and further readings
- Archana Lal, Naowarat Cheeptham. 2011. Phenylethyl alcohol agar protocol. American Society for Microbiology
- Clinical Microbiology Procedures Handbook, Fourth Edition. (2016). American Society of Microbiology. https://doi.org/10.1128/9781555818814